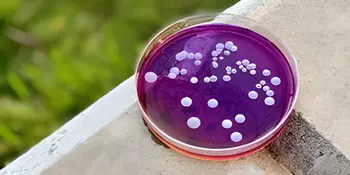
STEM Friday: March 13 - News Featured

Doc C. Locke Symposium March 18
March 5, 2020 NC State School of Education will present the third annual Don C. Locke Symposium at 4:00 p.m. on Wednesday, March 18, and it will be shown live via video stream in Ferguson Auditorium on the A-B Tech Asheville Campus. It is free and open to the public. No registration is required.
STEM Friday: March 13, 2020
March 5, 2020 The Science Behind Beer: Microbiological Techniques Applied Within the Brewing Industry, presented by Rachel Herndon, New Belgium Brewery, at noon on Friday, March 13, 2020, in Ferguson Auditorium.
A-B Tech Barber Academy Has Launched
February 7, 2020 Twenty new students joined Instructor Jay Kaufmann in the classroom of the Barber Academy on January 21 for its first class. The continuing education workforce training program will prepare students to apply for and pass the licensing examination offered by the North Carolina State Board of Barber Examiners (NCBBE).
Harvey Haynes, President Emeritus, dies at 89
February 6, 2020 Harvey Lee Haynes, 89, President Emeritus of A-B Tech, died January 12, 2020, after a brief illness. He was the College’s second president from 1975 to 1990. His career began at the College as counselor/coordinator of A-B Tech's predecessor, the Industrial Education Center.
60th Anniversary
February 6, 2020 A-B Tech is 60 this year, and we had a celebration on January 16 in the A-B Tech/Mission Health Conference Center. We had a chance to hear from President King, former President K. Ray Bailey, Dean Kenet Adamson, SGA President William Clinton, and SGA Vice President Michael McCrennan, who paid tribute to Dr. King and former President Harvey Haynes and celebrated 60 years in video, pictures, and stories.
King Named President of the Year, Receives Order of Long Leaf Pine
February 5, 2020 President Emeritus Dennis King was named NC Community College President of the Year and received other honors before his retirement.
Lewis and deVries Named Professor Emeriti
February 5, 2020 Charles deVries, Baking and Pastry Arts Instructor, and Lynn Lewis, Chemistry Instructor, are the latest instructors to be given the Professor Emeritus title. They will retire from their positions after the spring semester.
Rhymes Uses Personal Strengths to Organize Annual MLK Breakfast
February 5, 2020 Darryl Rhymes, Associate Director of Human Resources Special Assistant to the President for Inclusion, stays busy enough with his duties in his regular job hours at the college. However, he also teaches Continuing Education and Curriculum classes, rides his bicycle, and practices his singing.
Martin Luther King, Jr’s “The Other America”
February 2, 2020 It’s been 51 years since Dr. Martin Luther King, Jr., was assassinated on April 4, 1968. Prior to his death, Rev. Dr. Martin Luther King gave his “The Other America” speech to supporters participating in a celebratory “Salute to Freedom,” organized by the Local 1199 in New York City.
King Receives Miniature Engine Lathe as Retirement Gift
February 2, 2020 Retiring A-B Tech President Dennis King received a miniature engine lathe from the Computer Integrated Machining department on campus.